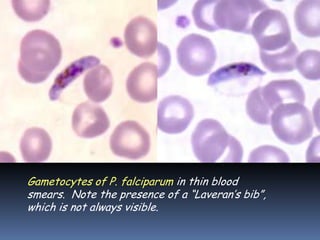
Gametocytes of P. falciparum in thin blood
smears. Note the presence of a “Laveran’s bib”,
which is not always visible.
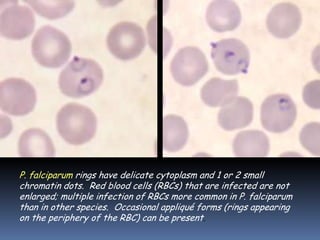
P. falciparum rings have delicate cytoplasm and 1 or 2 small
chromatin dots. Red blood cells (RBCs) that are infected are not
enlarged; multiple infection of RBCs more common in P. falciparum
than in other species. Occasional appliqué forms (rings appearing
on the periphery of the RBC) can be present.
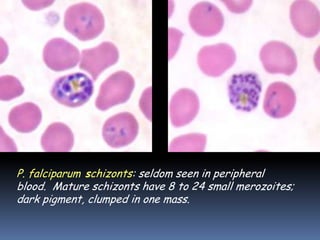
P. falciparum schizonts: seldom seen in peripheral
blood. Mature schizonts have 8 to 24 small merozoites;
dark pigment, clumped in one mass.
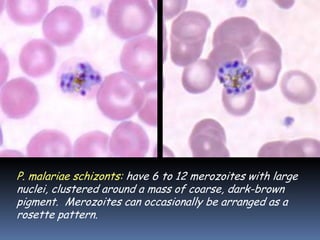
P. malariae schizonts: have 6 to 12 merozoites with large
nuclei, clustered around a mass of coarse, dark-brown
pigment. Merozoites can occasionally be arranged as a
rosette pattern.
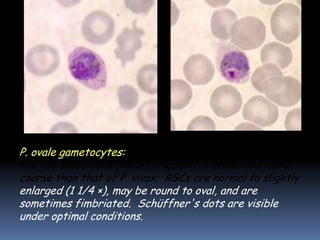
P. ovale gametocytes: round to oval, and may almost fill
the red blood cells (RBCs). Pigment is brown and more
coarse than that of P. vivax. RBCs are normal to slightly
enlarged (1 1/4 ×), may be round to oval, and are
sometimes fimbriated. Schüffner's dots are visible
under optimal conditions.
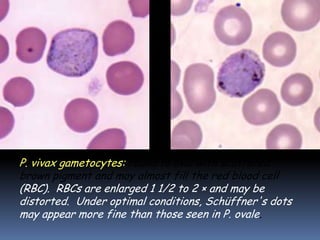
P. vivax gametocytes: round to oval with scattered
brown pigment and may almost fill the red blood cell
(RBC). RBCs are enlarged 1 1/2 to 2 × and may be
distorted. Under optimal conditions, Schüffner's dots
may appear more fine than those seen in P. ovale.
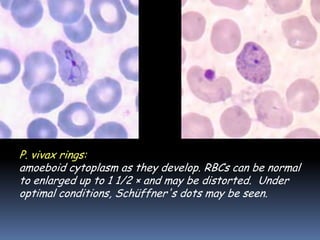
P. vivax rings: have large chromatin dots and can show
amoeboid cytoplasm as they develop. RBCs can be normal
to enlarged up to 1 1/2 × and may be distorted. Under
optimal conditions, Schüffner's dots may be seen.
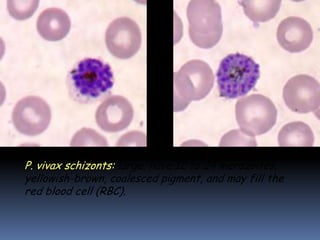
P. vivax schizonts: large, have 12 to 24 merozoites,
yellowish-brown, coalesced pigment, and may fill the
red blood cell (RBC).
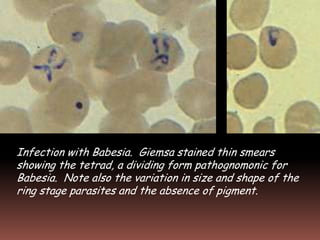
Infection with Babesia. Giemsa stained thin smears
showing the tetrad, a dividing form pathognomonic for
Babesia. Note also the variation in size and shape of the
ring stage parasites and the absence of pigment.

This document provides information on various microbial diseases that affect the cardiovascular and lymphatic systems. It discusses topics like sepsis, bacterial infections of the heart, rheumatic fever, tularemia, brucellosis, anthrax, biological weapons, gangrene, animal bites and scratches, plague, relapsing fever, Lyme disease, ehrlichiosis, typhus, spotted fevers, herpes virus infections, viral hemorrhagic fevers, Chagas disease, toxoplasmosis, malaria, and other protozoan infections. Detailed information is provided on the causative agents, symptoms, transmission, and microscopic images of pathogens for many of these diseases.